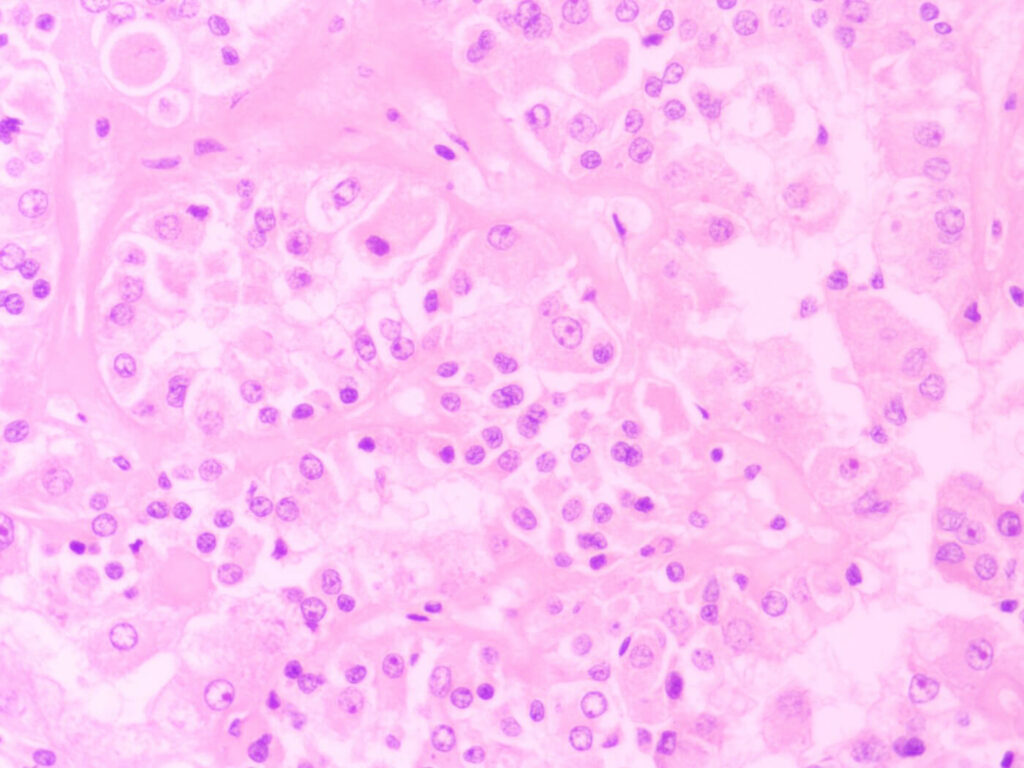

Histology
Histology (also known as surgical pathology, histopathology, anatomic pathology, microscopic anatomy) includes the processing & examination of surgical pathology specimens (surgical resections and biopsies) & autopsy pathology (tissue obtained at autopsy) specimens.
After the specimen is received in the histology lab, gross (macroscopic) examination is performed. The specimen is properly oriented, examined and appropriate representative section(s) taken, including surgical margins where appropriate.
The representative sections (or some small specimens in entirety) are then put in small cassettes and put through a series of processing steps. Ultra-thin slices of the tissue are then cut and put on glass slides. The tissue is stained and is then examined by pathologists to give a diagnosis.
The histology department processes numerous tissue specimens every year for examination & reporting by our pathologists.
Special histological procedures available include various special stains and immunohistochemistry (IHC) to further aid or refine diagnosis.
Second opinion consultation service on already processed & reported tissue specimens (blocks or slides) is available to external institutions/ clients on request.